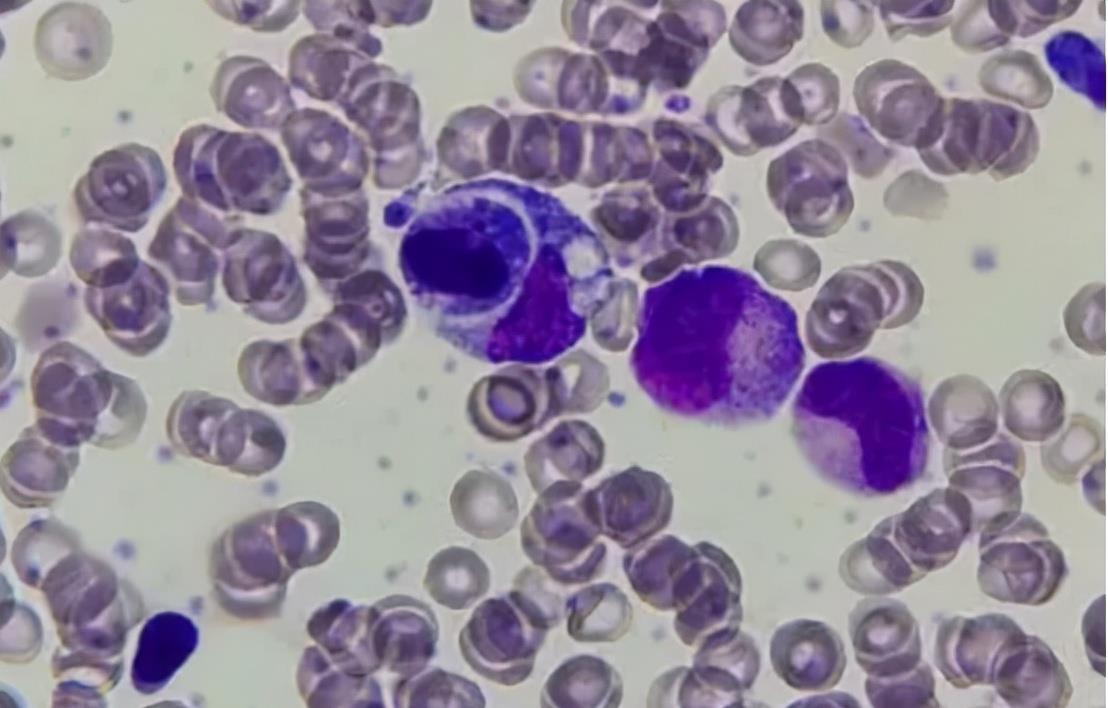

午美聊健康体态 吃降压药可能导致缺钾,比缺钙还危险,留意身体这4个症状

文章图片

文章图片
【午美聊健康体态 吃降压药可能导致缺钾,比缺钙还危险,留意身体这4个症状】

文章图片

文章图片

文章图片

文章图片
文章图片

高血压是一种严重危害全身性的疾病 , 一旦患上高血压 , 就必须要坚持用药治疗 , 同时还要定期去医院监测血压情况 , 给患者身体和心理造成一定负担 。 此外 , 治疗是一个漫长的过程 , 必须要依靠药物 , 但是有部分降压药物吃多了反而会有副作用 。
部分患者在服用降压药后会出现低钾血症 , 病发时身体会莫名的感到疲劳 , 这具体是怎么一回事情呢?实际上常用的降血压药物主要通过减少肾小管对钠的吸收 , 减少血容量 , 从而达到降血压的目的 , 但这一过程会导致人体钾的流失 , 引起身体出现不适 。
一、高血压的几个临床表现
高血压是导致心肌梗塞 , 脑梗 , 肾衰竭以及尿毒症的危险因素 , 是中老年朋友健康的罪魁祸首 , 因此必须要合理正确的服用降压药物 , 以达到降低血压的目的 。 据不完全统计 , 全国每年将近有百万人死于高血压或高血压相关的疾病 , 因此了解疾病相关症状非常重要 。
1.头晕
头晕是高血压最常见的一种现象 , 患者在发病期会感觉到头晕 , 分不清四周 , 甚至有的患者会出现眩晕的情况 , 分辨不清方向和人物面貌;发生头晕主要是由于血压过高引起脑动脉供血不畅 , 血压异常的话会引起脑细胞缺氧 , 血管壁紧张加厚 , 致使患者出现头晕的症状 。
另外 , 并非所有人都有头晕目眩的症状表现 。 少数人早期并无任何症状 , 随着病程的加剧 , 身体会逐步出现不适 , 直到去医院检查才明确患上高血压 。 因此 , 一旦发现可疑症状 , 应及时去医院做详细筛查 。
2.乏力
高血压患者在发病时会出现疲劳 , 乏力 , 困倦等临床表现 , 不同程度的病况症状表现不一;高血压患者经常会莫名的感到疲劳 , 疲倦 , 乏力等 , 有时候会有注意力不集中 , 做事情没有效率 , 间接影响到工作学习效率 。
高血压患者除了身体乏力之外 , 还会有类似感冒的症状 。 此时会经常有流鼻涕 , 打哈气 , 偶有发热的情况;少数患者还会出现四肢麻木 , 上下楼梯喘不过气来 , 精神萎靡等 。
3.流鼻血
高血压患者中 , 中老年人群是易发病人群 。 这类人群由于身体代谢功能差 , 血压升高时血管容易发生破裂 , 致使出现高血压 。 发病时 , 会出现流鼻血的症状 , 同时还会伴有口语不清 , 视力模糊 , 的情况 , 严重干扰中老年人正常生活 。
经验总结扩展阅读
- 什么家有柯基:柯基幼犬可以吃什么 小柯基吃什么又营养又健康?
- 东西方健康艳丽才是最好的,东西方的审美,是有很大差别的
- 2022最新早安图片带字不用打字聊天的冬天早上好问候祝福图片精选
- 运动 咖啡真的不健康吗?到底能不能减肥?
- 迷奸 初中生迷奸女教师,聊天记录:“我不想迷奸的,迷奸不会叫。”
- 人参“减法”更健康,参谷无硅油健康洗护挑战三大极致体验
- 血糖 糖尿病人建议要减肥,那如何才能健康安全的减肥呢?不妨看看!
- 2022清晨最美丽早安祝福语不用打字就可以聊天的早上好表情祝福语
- 进行肌肤更新的两大关键词
- 急救这些品牌面霜具有超强的修复能力,帮助缔造健康、富有弹性的肌肤










